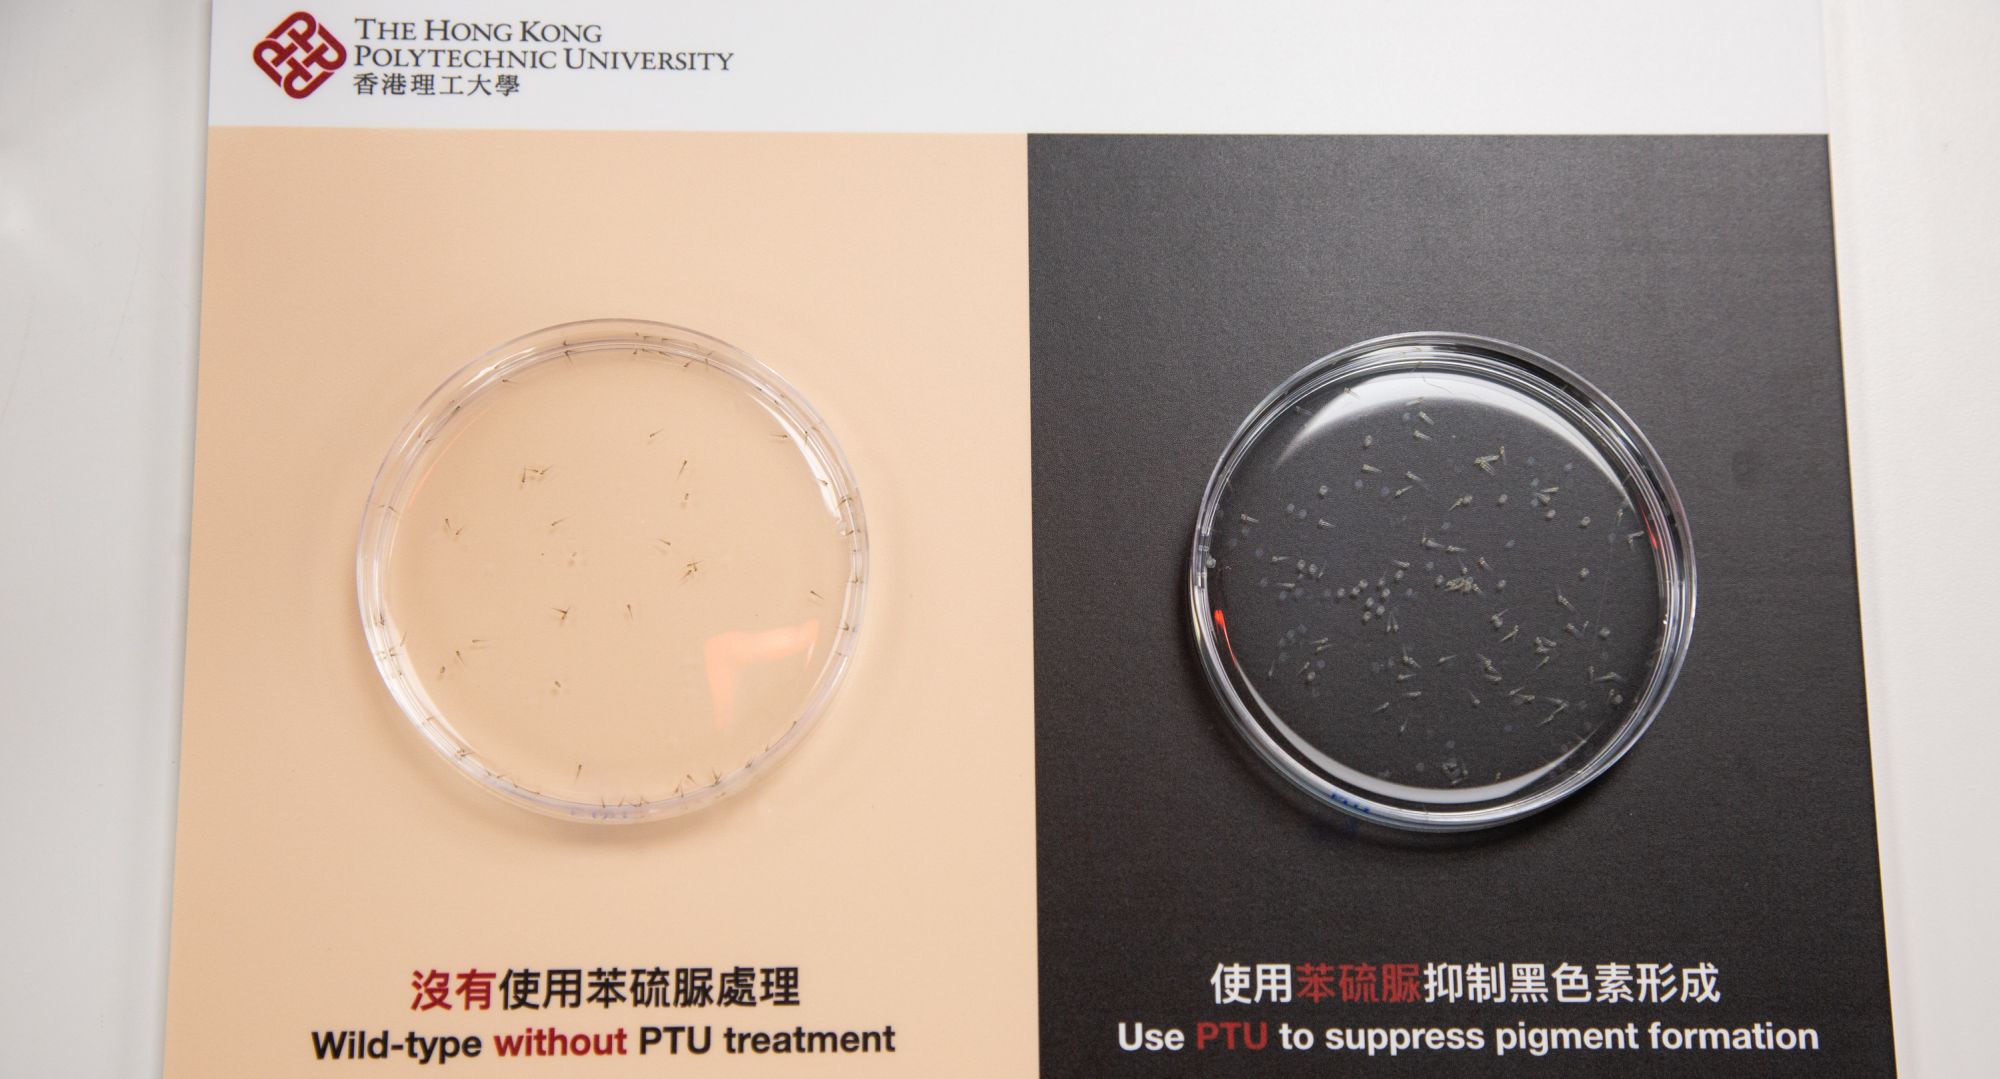
3

理大發現化學物苯硫脲激活斑馬魚胚胎細胞自噬 為癌症藥物科研方法帶來啟廸
全球利用斑馬魚作醫學科研近半個世紀,主要因為斑馬魚的基因與人類基因相似度逾七成,超過八成的人類疾病基因亦與至少一種斑馬魚直系同源基因有關。斑馬魚科研模型具有高通量的特性(即可以同時檢測大量基因數據,以進行篩選),作為試驗對象被廣泛應用在脊椎動物發展及癌症等疾病的研究,亦常用於研發及測試新藥物等項目之中。斑馬魚生長速度快、成本效益高亦容易養殖,故不少研究員經常採用斑馬魚進行科研。然而,香港理工大學(理大)醫療科技及資訊學系助理教授馬進恒博士及其團隊一項最新研究發現,以往經常用作抑制斑馬魚黑色素的化學物苯硫脲(PTU)會帶來副作用,並可能影響與細胞自噬相關的研究結果。這項嶄新的發現,為自噬研究的指引及正在進行的自噬及血液學研究帶來啟迪,研究人員或需重新審視與現有癌症治療藥物相關的研究。理大這項名為“1-phenyl 2-thiourea (PTU) Activates Autophagy in Zebrafish Embryos” 的研究文章 (文章連結),已於今年四月在國際學術期刊《自噬》(Autophagy) 上發表。
大部份利用斑馬魚進行的研究,均會使用化學物苯硫脲以抑制斑馬魚胚胎內的黑色素生長,令斑馬魚胚胎的光學透明度增加,方便於顯微鏡下攝取更佳的影像以作研究。過去三年,馬博士及其研究團隊亦以同樣方法研究白血病與細胞自噬的關係—細胞自噬是一種新陳代謝的機制,涉及細胞通過溶酶體機制分解,以及細胞更新再生的過程,亦會影響各種生理及病理狀況,包括細胞內物質更新、細胞死亡、增殖、發育、衰老和腫瘤形成等。
馬博士表示: 「於斑馬魚胚胎中加入0.003%苯硫脲,在斑馬魚的各種組織和器官中均可見自噬體及溶酶體出現異常,溶酶體堆積形成;在抑制斑馬魚胚胎黑色素的同時,自噬水平亦大幅提高。」他亦指出:「自噬在測試不同細胞抗藥性中擔當重要的角色,過度活躍的自噬活動可能會干擾藥物的成效。因此,以往利用加入苯硫脲的斑馬魚進行的自噬相關研究 (例如:癌症研究),未必能夠真實反映研究結果,或令結果有所偏差。這意味著研究員在未來需要避免使用苯硫脲進行與自噬相關的研究。」馬博士補充,其研究團隊已停止使用加入苯硫脲的斑馬魚進行白血病研究,並改用場深更厚的片層掃瞄顯微鏡(Light-Sheet microscopy),觀察正常斑馬魚胚胎中的自噬活動影像。
此外,是次研究結果亦提出了自噬及黑色素瘤之間的潛在關係,意味自噬可能透過與酪氨酸酶(一種調控黑色素合成的重要限速酶)的相互作用,影響黑色素瘤生長及抗藥性,未來亦會就自噬與黑色素瘤之間的關係進行更深入研究。
醫療科技及資訊學系系主任葉社平教授表示:「我們很高興團隊的研究成果能夠刊登於業界最具影響力的學術期刊《自噬》之內。馬博士更獲邀共同制定針對自噬研究的最新國際指引,相關指引每隔四年才會修訂一次。隨著新指引生效,我們得以採用更好的方法去研究斑馬魚及自噬有關的項目,並為各種致命疾病尋找新療法。」
***** 完 *****